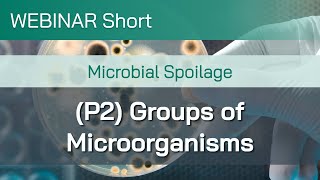

WEBINAR | Food Spoilage Microbiological Factors video
Online izle ve mp4 mp3 formatlarinda yukle

Videonun muddeti: 50:32
WEBINAR | Food Spoilage Microbiological Factors videosu mp4 ve mp3 yuklemek ucun hazirdir
Diqqet! Siz Mp4 yukle ve ya Mp3 yukle duymesine basdiqdan sonra eger sistem sizi reklam sehifesine atarsa o zaman derhal geri qayidib emeliyyati tekrar edin ve faylin yuklemek ucun hazir olmasini gozleyin
Videodan Mp4 Yukle
Videodan Mp3 Yukle-1
Videodan Mp3 Yukle-2
Oxshar Axtarishlar
 WEBINAR | Food Spoilage - Microbiological Factors
WEBINAR | Food Spoilage - Microbiological Factors WEBINAR | Shelf Life Part 1: Microbial Food Spoilage
WEBINAR | Shelf Life Part 1: Microbial Food Spoilage Food Spoilage | Foodborne Microbes | Foodborne Disease
Food Spoilage | Foodborne Microbes | Foodborne Disease MICROBIAL GROWTH & FOOD SPOILAGE | FOOD MICROBIOLOGY | BIOLOGY UNIVERSITY
MICROBIAL GROWTH & FOOD SPOILAGE | FOOD MICROBIOLOGY | BIOLOGY UNIVERSITY Webinar Short: Microbial Spoilage (P2): Groups of Microorganisms
Webinar Short: Microbial Spoilage (P2): Groups of Microorganisms Food Microbiology 101
Food Microbiology 101 FACTORS AFFECTING FOOD SPOILAGE | FOOD MICROBIOLOGY | BIOLOGY UNIVERSITY
FACTORS AFFECTING FOOD SPOILAGE | FOOD MICROBIOLOGY | BIOLOGY UNIVERSITY Webinar Short: Microbial Spoilage (Part 5): How Microorganisms Cause Food Spoilage
Webinar Short: Microbial Spoilage (Part 5): How Microorganisms Cause Food Spoilage SENIORS, STOP! 9 Foods Should NEVER Refrigerate (And What to Do Instead!) | Senior Health Tips
SENIORS, STOP! 9 Foods Should NEVER Refrigerate (And What to Do Instead!) | Senior Health Tips
Video Mp4 Mp3Azwap.Biz
Azwap.Biz 2021-2023


 WEBINAR | Food Spoilage - Microbiological Factors
WEBINAR | Food Spoilage - Microbiological Factors WEBINAR | Shelf Life Part 1: Microbial Food Spoilage
WEBINAR | Shelf Life Part 1: Microbial Food Spoilage Food Spoilage | Foodborne Microbes | Foodborne Disease
Food Spoilage | Foodborne Microbes | Foodborne Disease MICROBIAL GROWTH & FOOD SPOILAGE | FOOD MICROBIOLOGY | BIOLOGY UNIVERSITY
MICROBIAL GROWTH & FOOD SPOILAGE | FOOD MICROBIOLOGY | BIOLOGY UNIVERSITY Webinar Short: Microbial Spoilage (P2): Groups of Microorganisms
Webinar Short: Microbial Spoilage (P2): Groups of Microorganisms Food Microbiology 101
Food Microbiology 101 FACTORS AFFECTING FOOD SPOILAGE | FOOD MICROBIOLOGY | BIOLOGY UNIVERSITY
FACTORS AFFECTING FOOD SPOILAGE | FOOD MICROBIOLOGY | BIOLOGY UNIVERSITY Webinar Short: Microbial Spoilage (Part 5): How Microorganisms Cause Food Spoilage
Webinar Short: Microbial Spoilage (Part 5): How Microorganisms Cause Food Spoilage SENIORS, STOP! 9 Foods Should NEVER Refrigerate (And What to Do Instead!) | Senior Health Tips
SENIORS, STOP! 9 Foods Should NEVER Refrigerate (And What to Do Instead!) | Senior Health Tips